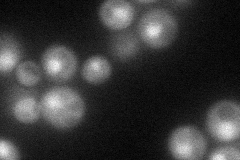
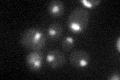

View description
Essential protein associated with the U1 snRNP complex; splicing factor involved in recognition of 5' splice site; contains two zinc finger motifs; N-terminal zinc finger binds pre-mRNA
Localization:
Intensity:
Fold change:
Significance:
-
C’ GFP library in SD

nucleus27.48 -
N' NOP1pr-GFP in SD
cytosol,nucleus60.2697 -
N' TEF2pr-mCherry in SD

nucleus48.158 -
N' NATIVEpr-GFP in SD

below threshold20.6579 -
N' TEF2pr-VC and Cyto-VN in SD

cytosol,nucleus31.5583 -
C’ GFP library in SD+DTT

nucleus32.671.18No -
C’ GFP library in SD+H2O2

nucleus27.861.01No -
C’ GFP library in Starvation Media
nucleus26.750.97No -
C’ GFP library on the background of Pup2-DaMP

nucleus -
C’ GFP library on the background of CCT mutant

nucleus25.18750.916279No
